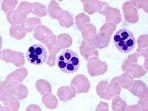
neutropenia-1.jpg

TAG
Neutropenia
Berita
-
Apa Itu Paracetamol ? Obat Demam yang Kini Ramai Diperbincangkan Lantaran Isu Gagal Ginjal Akut
Inilah hal-hal yang perlu kamu ketahui soal Paracetamol yang kini ramai diperbincangkan
-
Neutropenia
Neutropenia adalah kondisi yang terjadi ketika seseorang memiliki jumlah neutrofil dalam darah
Artikel TERKINI
-
Film - Pokun Roxy (2013)
Pokun Roxy adalah sebuah film horor komedi Indonesia yang dibintangi oleh Nikita -
Film - Malam 3 Yasinan
Malam 3 Yasinan adalah sebuah film horor Indonesia yang dibintangi oleh Shalom -
Film - Caleg by Accident
Caleg by Accident adalah sebuah film drama Indonesia yang dibintangi oleh Julia
© 2026 tribunnnewswiki.com,a subsidiary of KG Media.
All Right Reserved